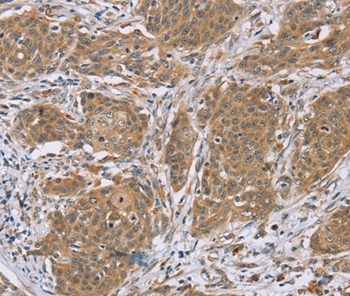

Goat anti-TRC8
EB05902
ApplicationsWestern Blot, ELISA, ImmunoHistoChemistry
Product group Antibodies
ReactivityCanine, Human
TargetRNF139
Overview
- SupplierEverest Biotech
- Product NameGoat anti-TRC8
- Delivery Days Customer5
- ApplicationsWestern Blot, ELISA, ImmunoHistoChemistry
- Applications SupplierPep-ELISA, WB, IHC
- CertificationResearch Use Only
- ClonalityPolyclonal
- Concentration0.5 mg/ml
- Gene ID11236
- Target nameRNF139
- Target descriptionring finger protein 139
- Target synonymsHRCA1, RCA1, TRC8, E3 ubiquitin-protein ligase RNF139, RING-type E3 ubiquitin transferase RNF139, multiple membrane spanning receptor TRC8, patched related protein translocated in renal cancer, translocation in renal carcinoma on chromosome 8 protein, translocation in renal carcinoma, chromosome 8
- HostGoat
- Scientific DescriptionRefSeq number(s): NP_009149.2. Purification: Antigen affinity purified. Names and symbols: RNF139; ring finger protein 139; TRC8; HRCA1; MGC31961; RCA1; patched related protein translocated in renal cancer; multiple membrane spanning receptor TRC8
- ReactivityCanine, Human
- Reactivity SupplierHuman, Dog
- Storage Instruction-20°C
- UNSPSC12352203